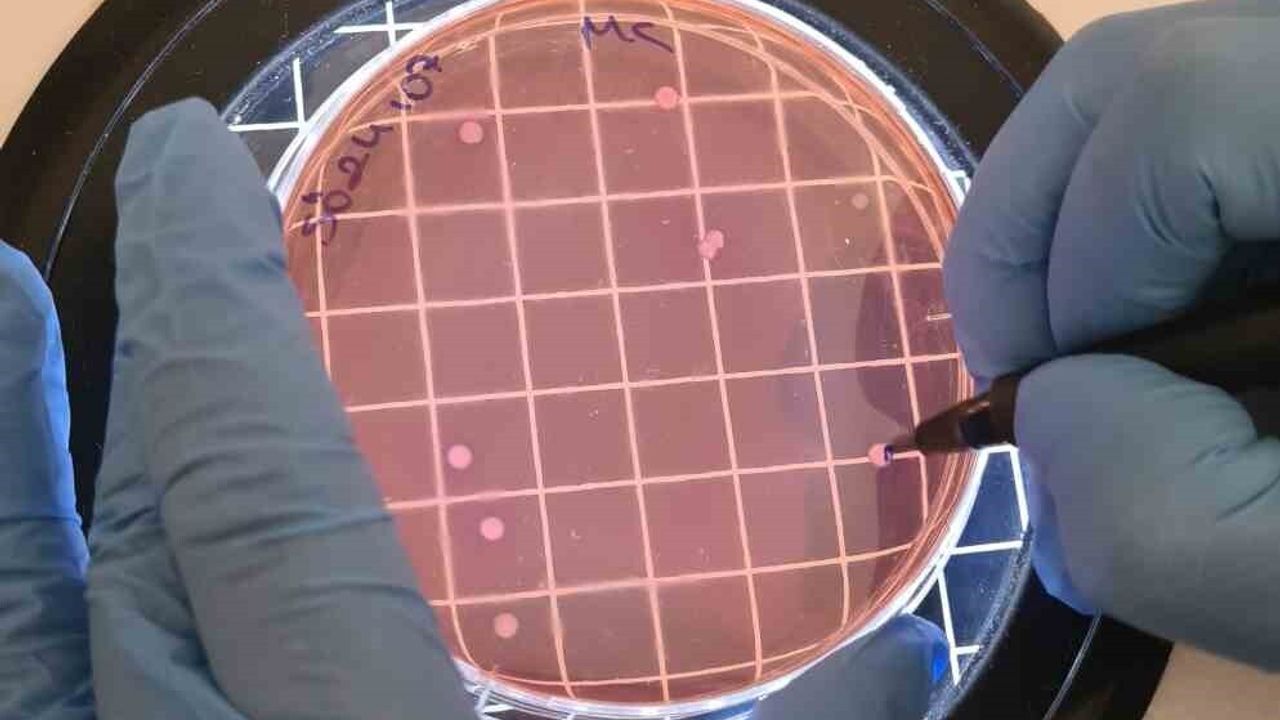
Çiğ Sütte UPEC Tehdidi: E. coli ve Antibiyotik Direnci

Çiğ Sütte UPEC Tehdidi: E. coli ve Antibiyotik Direnci
Araştırmanın özeti
İnönü Üniversitesi Fen-Edebiyat Fakültesi Biyoteknoloji Anabilim Dalı tarafından yürütülen çalışma, çiğ sütte var olan görünmez bakteriyel ekosistemin insan sağlığı açısından taşıdığı riskleri açığa çıkardı. Bilimsel Araştırma Projeleri (BAP) Birimi tarafından desteklenen 'Çiğ Süt Örneklerinde Escherichia coli Prevalansının ve Üropatojenik E. coli (UPEC) Virülans Genlerinin Araştırılması' başlıklı araştırma, Malatya kırsalından toplanan süt örneklerinde endişe verici sonuçlar ortaya koydu.
Başlıca bulgular
Araştırmada incelenen 122 çiğ süt örneği, özellikle Escherichia coli varlığı açısından yüksek oranlar gösterdi. Çarpıcı olan ise izolatların önemli bir kısmının, idrar yolu enfeksiyonlarına neden olabilen Üropatojenik E. coli (UPEC) suşlarına ait virülans genetik özelliklerini taşımasıydı. Çalışmada fimA ve agn43 genleri neredeyse tüm izolatlarda pozitif bulundu; bu genler bakterilere idrar yollarına tutunma, biyofilm oluşturma ve bağışıklıktan kaçma yetenekleri kazandırıyor.
Uzman yorumu
Çalışmanın yürütücüsü Doç. Dr. Seval Cing Yıldırım, bu bulguların insana geçen enfeksiyon riskini artırdığını vurguladı. Yıldırım, 'Çiğ süt, görünmez bir bakteri ekosistemi; bu ekosistemdeki bazı üyeler insan sağlığı açısından risk oluşturur. Süt aracılığıyla alınan bu bakteriler sessizce üriner sisteme ulaşıp enfeksiyon oluşturabilirler. Özellikle kadınlar, yaşlı bireyler ve bağışıklığı zayıf kişiler için risk söz konusudur' ifadelerini kullandı.
Antibiyotik direnci ve denetim uyarısı
Doç. Dr. Yıldırım, mevcut denetim sistemlerinin hâlâ 'bakteri var mı yok mu?' yaklaşımıyla sınırlı olduğunu belirterek moleküler patojenite analizleri ve antimikrobiyal direnç taramalarının rutin gıda kontrollerine eklenmesi gerektiğini söyledi. Ayrıca tüm izolatların sefalotin antibiyotiğine dirençli olduğuna ve çoklu antibiyotik direncinin varlığına dikkat çekti. Yıldırım bu durumu, 'Çiftlikten sofraya uzanan çok yönlü bir direnç zinciri' olarak tanımladı.
Isıl işlem ve hijyenin önemi
Isıl işlemlerin bakteriler üzerindeki etkisine değinen Yıldırım, 'Pastörizasyon ve kaynatma büyük oranda etkilidir; ancak sağımdan depolamaya, taşımadan işleme ve satışa kadar uzanan hijyen zinciri doğru işletilmezse risk maalesef sıfırlanmaz. Çiğ sütten yapılan peynirlerde uygulanan ısıl işlemler kısa süreli olduğu ve yeterli sıcaklığa ulaşmadığı için, dirençli bakterileri ve virülans genlerini tamamen elimine etmek her zaman mümkün değildir' uyarısında bulundu. Hedeflerinin korku yaratmak değil, bilimsel kanıtlarla desteklenen farkındalık oluşturmak olduğunu ekledi.
Çalışma süreci ve işbirlikleri
Araştırmada görev alan İnönü Üniversitesi yüksek lisans öğrencisi Aynur Akan, Malatya kırsalından 6 ay içinde toplanan 122 çiğ süt örneğinin incelendiğini belirtti. Proje kapsamındaki çalışmaların bir kısmının Sinop Üniversitesi'nde yürütüldüğünü söyleyen Akan, 'Çalışmaların bir kısmı İnönü Üniversitesi Fen Edebiyat Fakültesi Biyoloji Bölümü Endüstriyel Biyoteknoloji Araştırma Laboratuvarı'nda gerçekleştirilirken bir kısmı da Sinop Üniversitesi öğretim üyeleri Doç. Dr. Zeynep Yeğin ve Dr. Öğr. Üyesi Cumhur Avşar ile yapıldı. Bilimsel Araştırma Projeleri Birimi'ne desteklerinden ötürü teşekkür ederim' dedi.
Sonuç
Çalışma, çiğ süt ve süt ürünlerinin mikrobiyolojik güvenliğinin yalnızca varlık-yokluk kontrolüyle sağlanamayacağını; moleküler patojenite, antimikrobiyal direnç izleme, hijyen zinciri ve uygun ısıl işlemlerin entegre edilmesinin gerekliliğini ortaya koyuyor. Bu bulgular, gıda güvenliği politikalarında güncelleme ve daha kapsamlı denetim mekanizmaları ihtiyacını gündeme taşıyor.

İNÖNÜ ÜNİVERSİTESİ FEN-EDEBİYAT FAKÜLTESİ BİYOTEKNOLOJİ ANABİLİM DALI TARAFINDAN ÇİĞ SÜT ÜZERİNE YAPILAN ÇALIŞMA GÖRÜNMEZ BİR BAKTERİ EKOSİSTEMİNİ ORTAYA KOYDU. SÜT ARACILIĞIYLA VÜCUDA GİREN BU SİSTEMDEKİ BAKTERİLER SESSİZCE ÜRİNER SİSTEME ULAŞIP ENFEKSİYON OLUŞTURABİLİYOR.





